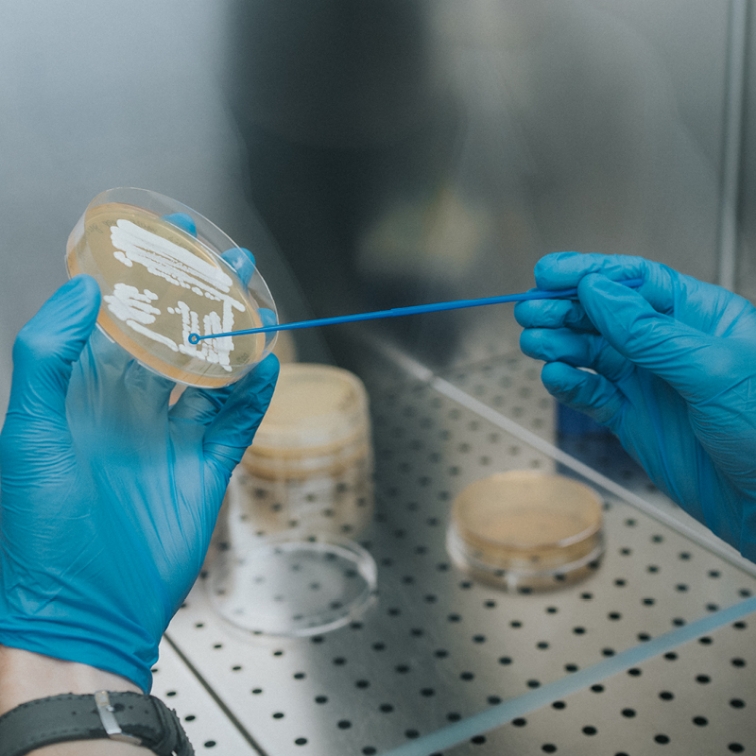

Production and Characterization of Nanoparticles
SYNTHESIS OF NANOPARTICLES
- LNP process development (Sunshine, Unchained Labs)
- Microfluidic system for nanoparticles production (Dolomite)
- Microwave Synthesizers (Discover 2.0, CEM)
PURIFICATION PROCESSES
- Automated Tangential Flow Filtration (KrosFlo® Research 2i, Repligen – 5 mL-10 L)
- Ultracentrifuge (Optima™ XPN, 100k RPM, Beckman)
CHARACTERIZATION
- Dynamic Light Scattering/Zeta Potential Analyzer (Zetasizer Ultra Red, Malvern)
- Nanoparticle Tracking Analyzer (Nanosight Pro, Malvern)
- Differential Centrifugal Sedimentation (CPS Disc Centrifuge DC24000, CPS instruments)
- High Performance Liquid Chromatography (HPLC, 1260 Infinity II, Agilent)
- Benchtop NMR system (Minispec MQ20)
- FT-IR Spectofotometer (INVENIO®, Bruker)
- Bench Scanning Electron Microscope (Phenom Pro G6, ThermoFisher Scientific)
- Fluorimeter (FluoroMax-4P, Horiba)
- Freeze dryer (Deltek)
Biological and cellular studies
- Live-Cell Imaging and Analysis (Incucyte SX5®, Sartorius)
- Multimode Plate Reader – Abs, Fluorescence, Luminescence (Ensight, Perkin Elmer)
- Hyperspectral Microscope (Cytoviva, Cytoviva®)
- Flow cytometer (Cytek Aurora, Cytek®)
- Smart Cell Imager (Paula, Leica)
Production and characterization of solid and semisolid dosage forms
PRODUCTION
- 3D printing - Binder Jetting Technology (Armadillo, Concr3de)
- Tablet press (Glatt)
- Coating Machine (Glatt)
CHARACTERIZATION
- Rheometer (MCR 92, Anton Paar)
- Texture Analyzer (TA.XT Plus C, Enco)
Other instruments (visit NanoCosPha website)
EFFICACY ANALYSIS OF COSMETICS
- Cutometer® dual MPA 580 (Courage + Khazaka Electronic) with different probes
- VISIOSCAN® VC 20PLUS (Courage + Khazaka Electronic)
- ULTRASCAN UC22 (Courage + Khazaka Electronic)
- Visia-7 Deluxe AIO
Facilities
- Confocal Microscope (Nikon A1, Nikon)
- Thunder Imager Live cell & 3D (Leica)
- TEM (Jeol JEM 2100Plus, Jeol)
- High Content Analysis System (Operetta CLS, Perkin Elmer)
- FPLC (GE AKTA Purifier 100, Marshall Scientific)